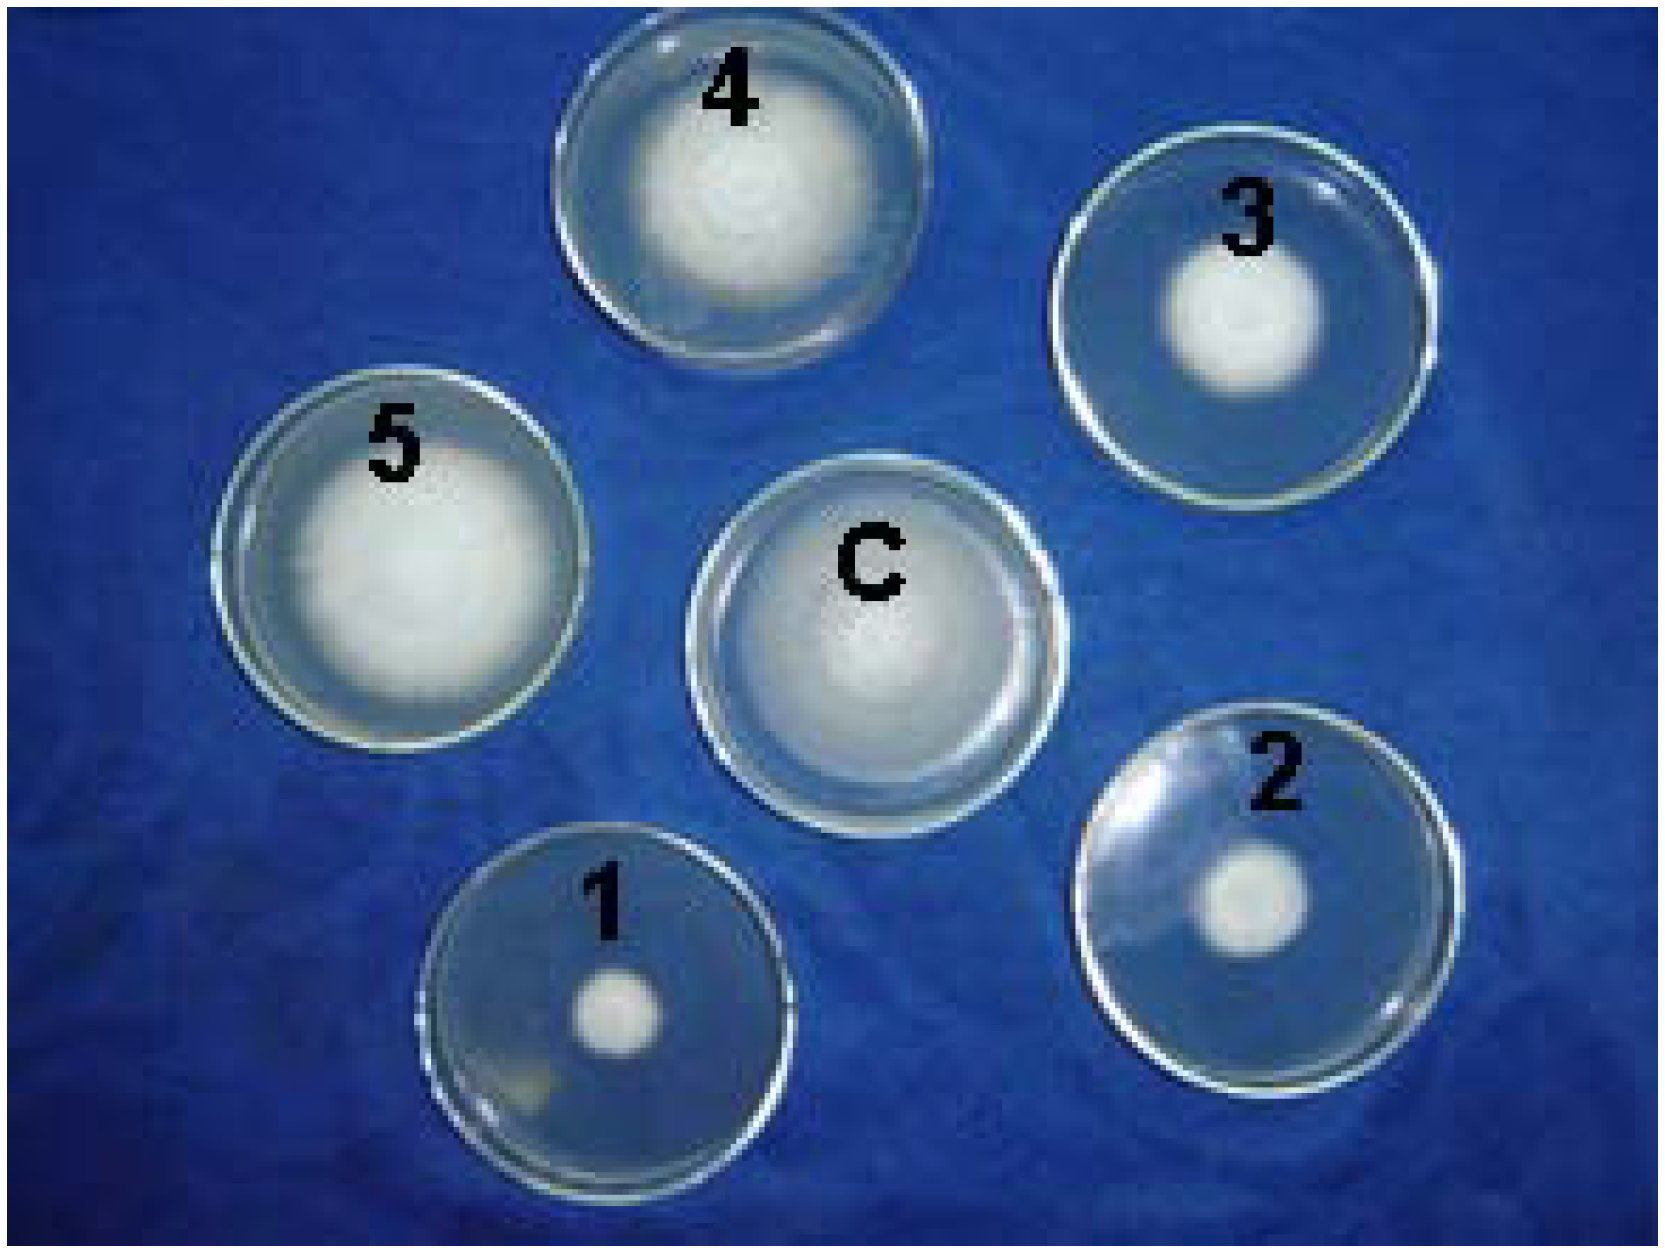
Molecules 12 00965 g001

Synthesis, Antiviral and Antifungal Bioactivity of 2-Cyano-acrylate Derivatives Containing Phosphonyl Moieties
Abstract
:Introduction

Results and Discussion
| Entry | Solvent | Ratio a | Time (h) | Reaction temperature | Yield (%) b |
|---|---|---|---|---|---|
| 1 | DMF | 1:3:3 | 16 | r.t | 11.2 |
| 2 | acetone | 1:3:3 | 16 | r.t | 19.0 |
| 3 | CH3CN | 1:3:3 | 16 | r.t | 34.9 |
| 4 | THF | 1:3:3 | 16 | r.t | 55.0 |
| 5 | THF | 1:3:1 | 16 | r.t | 12.0 |
| 6 | THF | 1:3:2 | 16 | r.t | 20.0 |
| 7 | THF | 1:1:1 | 16 | r.t | 0 |
| 8 | THF | 1:3:4 | 16 | r.t | 49.5 |
| 9 | THF | 1:3:3 | 4 | r.t | 0 |
| 10 | THF | 1:3:3 | 8 | r.t | 23.0 |
| 11 | THF | 1:3:3 | 20 | r.t | 56.0 |
| 12 | THF | 1:3:3 | 16 | 0-5°C | 23.0 |
| 13 | THF | 1:3:3 | 16 | 40-45°C | 13.0 |
Antifungal Bioassay: Inhibitory effects of cyanoacrylate derivatives on phytopathogenic fungi
| Compd. | Conc. (μg/mL) | Inhibition rate (%) | ||||||
|---|---|---|---|---|---|---|---|---|
| Fusarium graminearum | Cytospora mandshurica | Fusarium oxysporum | ||||||
| 2a | 50 | 11.14±0.21 | 11.00±0.25 | 18.21±0.11 | ||||
| 500 | 37.30±0.56 | 24.00±0.77 | 26.03±0.99 | |||||
| 2b | 50 | 4.94±0.49 | 1.34±0.65 | 8.08±0.98 | ||||
| 500 | 31.40±0.78 | 35.03±0.84 | 36.83±1.24 | |||||
| 2c | 50 | 8.31±0.57 | 13.10±0.78 | 13.47±1.24 | ||||
| 500 | 37.10±1.08 | 31.82±1.45 | 41.02±1.30 | |||||
| 2d | 50 | 64.50±0.40 | 60.43±0.63 | 65.03±1.22 | ||||
| 500 | 93.30±4.28 | 90.59±1.59 | 92.75±2.52 | |||||
| 2e | 50 | 22.04±0.90 | 32.01±0.78 | 26.71±0.90 | ||||
| 500 | 41.44±1.21 | 36.77±1.45 | 32.13±1.09 | |||||
| 2f | 50 | 35.22±1.78 | 41.09±3.21 | 46.11±3.34 | ||||
| 500 | 55.64±3.01 | 66.09±2.55 | 68.9±1.19 | |||||
| 2g | 50 | 7.79±0.57 | -0.80±0.72 | 6.29±0.97 | ||||
| 500 | 40.0±2.15 | 49.47±1.01 | 48.80±1.33 | |||||
| 2h | 50 | 4.68±0.56 | -3.21±0.85 | 5.99±0.87 | ||||
| 500 | 25.41±0.73 | 23.26±0.84 | 36.53±1.27 | |||||
| 2i | 50 | 5.45±0.73 | -2.67±0.67 | 1.20±0.89 | ||||
| 500 | 16.3±0.64 | 8.29±0.76 | 20.06±0.97 | |||||
| 2j | 50 | 0.97±0.11 | 11.27±0.45 | 9.99±0.22 | ||||
| 500 | 20.00±0.21 | 26.78±0.44 | 30.99±1.09 | |||||
| 2k | 50 | 10.09±0.76 | 32.20±0.55 | 19.39±0.44 | ||||
| 500 | 31.03±0.90 | 36.38±1.32 | 40.22±1.45 | |||||
| 2l | 50 | 21.08±0.98 | 30.07±0.67 | 12.11±1.02 | ||||
| 500 | 34.01±1.67 | 29.51±1.02 | 32.00±0.69 | |||||
| 2m | 50 | 3.93±0.22 | 14.23±0.51 | 23.09±0.88 | ||||
| 500 | 27.31±0.99 | 16.08±0.55 | 41.90±2.01 | |||||
| 2n | 50 | 12.22±1.01 | 9.97±0.88 | 11.91±0.42 | ||||
| 500 | 24.04±0.62 | 36.09±0.55 | 35.69±1.90 | |||||
| 2o | 50 | 3.75±0.52 | 10.61±0.69 | 4.01±0.55 | ||||
| 500 | 21.08±0.65 | 48.28±0.96 | 29.07±0.65 | |||||
| 2p | 50 | 4.45±0.55 | 24.93±0.76 | 6.52±0.56 | ||||
| 500 | 28.10±0.69 | 47.21±0.95 | 35.59±0.69 | |||||
| 2q | 50 | 7.03±0.60 | 15.38±0.61 | 3.26±0.44 | ||||
| 500 | 42.15±0.79 | 57.82±1.11 | 33.58±0.68 | |||||
| 2r | 50 | 11.71±0.96 | 23.87±0.75 | 9.52±0.57 | ||||
| 500 | 44.03±0.81 | 64.72±1.26 | 52.13±0.84 | |||||
| 2s | 50 | 9.84±0.61 | 35.01±0.72 | 13.53±0.48 | ||||
| 500 | 53.40±0.92 | 65.78±1.29 | 56.64±0.90 | |||||
| 2t | 50 | 49.67±0.65 | 51.30±0.70 | 41.05±0.51 | ||||
| 500 | 81.97±2.91 | 75.33±1.71 | 69.42±1.23 | |||||
| Hymexazol a | 50 | 73.2±1.41 | 58.89±1.16 | 65.51±1.76 | ||||
| 500 | 100±0.66 | 95.33±1.87 | 93.18±3.76 | |||||
| DMSO b | 0 | 0 | 0 | |||||
Micro-observation results

Conclusions
Experimental
General
General procedure for the preparation of title compounds 2a-2t.
Yields and product characterization
Antifungal bioassay
Hyphal morphology of F. oxysporum
Acknowledgments
References
- Mackay, S. P.; O’Malley, P. J. Z. Molecular modelling of the interaction between DCMU and the Q(B)-binding site of photosystem-II. Z. Naturforsch. 1993, 48c, 191–198. [Google Scholar]
- Huppatz, J. L.; Phillips, J. N.; Rattigan, B. M. Cyanoacrylates. Herbicidal and photosynthetic inhibitory activity. Agric. Biol. Chem. 1981, 45, 2769–2773. [Google Scholar] [CrossRef]
- Wang, Q. M.; Li, H.; Li, Y. H.; Huang, R. Q. Synthesis and herbicidal activity of 2-cyano-3- (2-chlorothiazol-5-yl)methylaminoacrylates. J. Agric. Food Chem. 2004, 52, 1918–1922. [Google Scholar] [CrossRef]
- Wang, L. G.; Wang, F. Y.; Diao, Y. M.; Ni, Y. P.; Wei, P. Synthesis and fungicidal activity of ethyl 2-cyano-3-substituted-amino-3-(2-methylphenyl)propenoate. Chin. J. Org. Chem. 2005, 25, 1254–1258. [Google Scholar]
- Song, B. A.; Yang, S.; Zhong, H. M.; Jin, L. H.; Hu, D. Y.; Liu, G. Synthesis and bioactivity of 2-cyanoacrylates containing a trifluoromethylphenyl moiety. J. Fluorine Chem. 2005, 126, 87–92. [Google Scholar] [CrossRef]
- Zhang, H. P.; Song, B. A.; Zhong, H. M.; Yang, S.; Jin, L. H.; Hu, D. Y.; He, W. Synthesis of 2-cyanoacrylates containing pyridinyl moiety under ultrasound irradiation. J. Heterocyclic Chem. 2005, 42, 1211–1214. [Google Scholar]
- Song, B. A.; Zhang, H. P.; Wang, H.; Yang, S.; Jin, L. H.; Hu, D. Y.; Pang, L. L.; Xue, W. Synthesis and antiviral activity of novel chiral cyanoacrylate derivatives. J.Agric.Food Chem. 2005, 53, 7886–7891. [Google Scholar]
- Boehner, B.; Hall, R. G. Preparation of pyrazolylphosphonate pestcides. DE 4139849 1992. [Chem. Abstr. 1992, 117, 131386n]. [Google Scholar]
- Cross, H.; Koeckritz, A.; Scheidecker, S.; Schnell, M. Preparation of dialkyl 5-aminooxazole-5- phosphonates. DE 4108345 1992. [Chem. Abstr 1992, 117, 251560 m]. [Google Scholar]
- Fouque, D.; About-Jaudet, E.; Collignon, N. Alpha-pyrazolyl-alkylphosphonates. Part II: a simple and efficient synthesis of diethyl-1-(pyrazol-4-yl)-alkyl phosphonates. Synth. Commun. 1995, 25, 3443–3455. [Google Scholar] [CrossRef]
- Huang, W. S.; Yuan, C.Y. Studies on organophosphorus compounds 92: a facile synthesis of 1-substituted-5-trifluoromethylimidazole-4-phosphonates. Synthesis 1996, 4, 511–513. [Google Scholar] [CrossRef]
- Lu, R. J.; Yang, H. Z. A novel approach to phosphonyl-substituted heterocyclic system (I). Tetrahedron Lett. 1997, 8, 5201–5204. [Google Scholar] Chen, K.; Hu, F. Z.; Zhang, J. H.; Wu, C.; Yang, H. Z. Progress in the synthetic methods of phosphonyl heterocyclic compouds. Chin. J. Org. Chem. 2000, 20, 866–873. [Google Scholar]
- Chen, K.; Yang, H. Z.; Liu, Z.; Hu, F. Z.; Zhang, C. X. Synthesis of Novel Phosphonyl/ S-methyl Ketene Thioacetals and N-Substituted Phosphonyl/S-methyl Thiocarbonates under Microwave Irradiation. Chin. J. Org. Chem. 2001, 21, 690–692. [Google Scholar]
- McCombie, H.; Sauders, B. C.; Stacey, G. J. Esters containing phosphorus Part I. J. Chem. Soc. 1945, 380–382. [Google Scholar] [CrossRef]
- Liu, H.-Y.; Sha, Y.-L.; Dai, G. - X.; Tan, H. -F.; Yang, H.-Z.; Lai, L.-H. J. Synthesis of novel derivatives of 2-cyano-3-methylthio-3'-benzylamino-acrylates (acryl, amides) and their biological activity. Phosphorus, Sulfur Silicon 1999, 148, 235–241. [Google Scholar] [CrossRef]
- Erwin, D. C.; Sims, J. J.; Borum, D. E; Childers, J. R. Detection of the systemic fungicide, thiabendazole, in cotton plants and soil by chemical analysis and bioassay. Phytopathology 1971, 61, 964–967. [Google Scholar] [CrossRef]
- Yang, S.; Gao, X. W.; Diao, C. L.; Song, B. A.; Jin, L. H.; Xu, G. F.; Zhang, G. P.; Wang, W.; Hu, D. Y.; Xue, W.; Zhou, X.; Lu, P. Synthesis and antifungal activity of novel chiral α-amino- phosphonates containing fluorine moiety. Chin. J. Chem. 2006, 24, 1581–1588. [Google Scholar]
- Gooding, G. V., Jr.; Hebert, T. T. A simple technique for purification of tobacco mosaic virus in large quantities. Phytopathology 1967, 57, 1285–1290. [Google Scholar]
- Sample Availability: Samples of the compounds are available from authors.
© 2007 by MDPI (http://www.mdpi.org). Reproduction is permitted for noncommercial purposes.
Share and Cite
Lv, Y.-P.; Wang, X.-Y.; Song, B.-A.; Yang, S.; Yan, K.; Xu, G.-F.; Bhadury, P.S.; Liu, F.; Jin, L.-H.; Hu, D.-Y. Synthesis, Antiviral and Antifungal Bioactivity of 2-Cyano-acrylate Derivatives Containing Phosphonyl Moieties. Molecules 2007, 12, 965-978. https://doi.org/10.3390/12050965
Lv Y-P, Wang X-Y, Song B-A, Yang S, Yan K, Xu G-F, Bhadury PS, Liu F, Jin L-H, Hu D-Y. Synthesis, Antiviral and Antifungal Bioactivity of 2-Cyano-acrylate Derivatives Containing Phosphonyl Moieties. Molecules. 2007; 12(5):965-978. https://doi.org/10.3390/12050965
Chicago/Turabian StyleLv, Yin-Pu, Xian-You Wang, Bao-An Song, Song Yang, Kai Yan, Guang-Fang Xu, Pinaki S Bhadury, Fang Liu, Lin-Hong Jin, and De-Yu Hu. 2007. "Synthesis, Antiviral and Antifungal Bioactivity of 2-Cyano-acrylate Derivatives Containing Phosphonyl Moieties" Molecules 12, no. 5: 965-978. https://doi.org/10.3390/12050965
APA StyleLv, Y.-P., Wang, X.-Y., Song, B.-A., Yang, S., Yan, K., Xu, G.-F., Bhadury, P. S., Liu, F., Jin, L.-H., & Hu, D.-Y. (2007). Synthesis, Antiviral and Antifungal Bioactivity of 2-Cyano-acrylate Derivatives Containing Phosphonyl Moieties. Molecules, 12(5), 965-978. https://doi.org/10.3390/12050965



